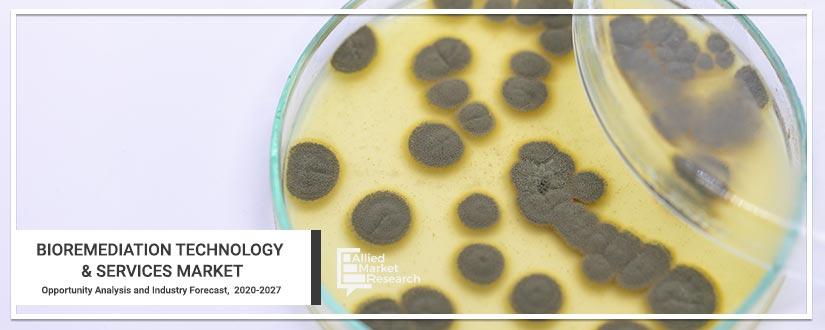
Bioremediation-Technology-&-Services

Bioremediation encompasses making use of micro-organisms, which can assist in the neutralization or removal of various contaminants by using waste. This technique also utilizes organisms available in nature, which crash materials that are hazardous to non-toxic as well as less toxic substances. Bioremediation is very important where chemicals aren’t used and also allows the waste in recycling after the contaminants are neutralized or removed. Soil remediation reduces the concentration of the contaminants in the soil. Soil remediation is necessary when the hydrocarbons concentration in the soil increases and affects the health of humans. Wastewater remediation traces the water pollutants and monitors them. The common techniques used biologically are physiochemical and treatment common technologies used during wastewater treatment. The government has been focusing on various new programs and initiatives to address various issues of contamination and keep the tracks of bioremediation techniques.
The U.S. government has formed an agency Environment Protection Authority (EPA), which works for the treatment and evaluation of the regions contaminated all over the world. Environment Protection Authority also runs a program “Superfund”, which helps in cleansing the contaminated regions in all parts of the U.S.
COVID-19 scenario analysis:
- To take care of the infected population, the demand for medical supplies is increasing. Respiratory support devices, such as atomizer, life-support machine, oxygen generator, and monitor, are among the majorly used medical devices in primary clinical treatment.
- Moreover, COVID-19 has led to a huge surge in demand for medical supplies such as personal protective equipment including masks, gloves, and protective eyeglasses. With rise in the number of COVID-19 cases worldwide, the need for medical supplies keeps on rising both from healthcare professionals and civil populations for precautionary measures.
- Manufacturers of these products have a chance to capitalize on this increased demand for medical supplies to ensure adequate and continuous supply of personal protective equipment in the market.
- Attributed to such factors, COVID-19 is expected to have a significant impact on the market.
Top impacting factors: Market scenario analysis, trends, drivers, and impact analysis
Growth in urbanization, upgrades in technologies, and industrialization have disturbed the balance in the nature along with creating various problems such as disparity in the ecological processes of soil, uncertain changes in the soil, and global warming. Continuous deposition of compounds for xenobiotic recalcitrant in the habitat leads to hazardous effects, which encourage various strategies and techniques for the disposition, thereby propelling the growth of the bioremediation market. In the recent years, the demand for bioremediation is rising, owing to the increasing popularity of the strategies. Advancements in technology and services have been observed along with rise in application of bioaugmentation, biostimulation, fungal remediation, bioreactors, phytoremediation, and land-based remediation.
As the water resources available are very low, farmers in the seri-urban as well as urban areas use high amount of pesticides and heavy metals, which contaminate the water used for the irrigation process and results in toxicity of plants. This is a huge risk for human health and encourages the need for new techniques in the bioremediation technology.
New product launches to boost the market
On May 21st, 2020, Wells Fargo Innovation Incubator, a technology incubator and platform declared that Pluton Biosciences will be the member of the IN2’s seventh cohort.
Surge in usage in commercial applications
Bioremediation technology is been used in both commercial as well as in residential areas. These devices are used to free various oilfields, fungal, soil as well as wastewater remediation. An increase in global warming and contamination of ecological factors rise the demand for bioremediation devices.
Key benefits of the report:
- This study presents the analytical depiction of the bioremediation technology & services market along with the current trends and future estimations to determine the imminent investment pockets.
- The report presents information related to key drivers, restraints, and opportunities along with detailed analysis of the bioremediation technology & services market share.
- The current market is quantitatively analyzed to highlight the bioremediation technology & services market growth scenario.
- Porter’s five forces analysis illustrates the potency of buyers & suppliers in the market.
- The report provides a detailed bioremediation technology & services market analysis based on competitive intensity and how the competition will take shape in coming years.
Questions answered in the bioremediation technology & services market research report:
- Which are the leading market players active in the bioremediation technology & services market?
- What are the current trends that will influence the market in the next few years?
- What are the driving factors, restraints, and opportunities of the market?
- What are the projections for the future that would help in taking further strategic steps?
Bioremediation Technology & Services Market Report Highlights
| Aspects | Details |
| By Type |
|
| By Technology |
|
| By Services |
|
| By End User |
|
| By Region |
|
| Key Market Players | Ivey International, Inc., Altogen Labs, Drylet LLC, REGENESIS, InSitu Remediation Services Limited, Sumas Remediation Services, Inc., Xylem, Inc., Sarva Bio Remed, LLC., PROBIOSPHERE, Aquatech International LLC |
Loading Table Of Content...